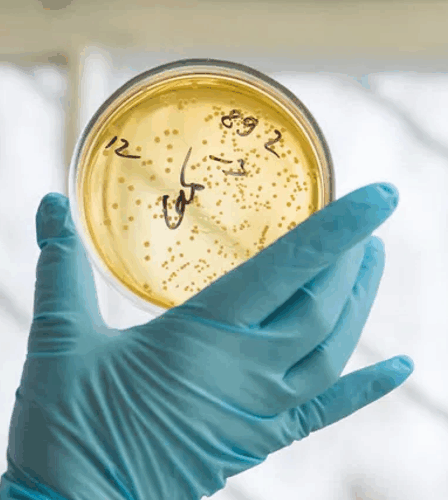

Estudo na íntegra: https://pmc.ncbi.nlm.nih.gov/articles/PMC9839457/ (Tradução do resumo do artigo científico): Resumo: A inalação, nebulização e irrigação de solução de nanoprata foram clinicamente benéficas para o tratamento de sinusite fúngica, pneumonia MDR e COVID-19. O tratamento parece atuar nos tecidos epiteliais, impedindo o sistema imunológico de iniciar/continuar uma tempestade de citocinas ou bradicininas ao amortecer a resposta imune, prevenindo assim a destruição …
Sinusite, Rinite, Pneumonia e Covid-19
Prata coloidal combate Pseudomonas aeruginosa patogênica e MRSA (tipo de bactéria resistente a alguns tipos de antibióticos) na rinossinusite crônica
Estudo na íntegra: https://pubmed.ncbi.nlm.nih.gov/33690064/ (Tradução do resumo do artigo científico): O surgimento de bactérias resistentes a antibióticos requer o desenvolvimento de novos compostos antimicrobianos, um dos quais a prata coloidal com fortes propriedades bactericidas e sendo as nanopartículas inorgânicas mais promissoras para o tratamento de doenças infecciosas bacterianas. No entanto, a sua produção pode ser lenta e complicada. Aqui, utilizamos extrato …
Prata coloidal: um novo tratamento para biofilmes de Staphylococcus aureus?
Estudo na íntegra: https://pubmed.ncbi.nlm.nih.gov/24431107/ (Tradução do resumo do artigo científico): Antecedentes: A prata coloidal é uma medicina alternativa que consiste em partículas de prata suspensas em água. Depois de usar esta solução como spray nasal, observou-se que os sintomas de um paciente com rinossinusite crônica previamente recalcitrante infectado por Staphylococcus aureus (S. aureus) melhoraram acentuadamente. O objetivo deste estudo foi determinar se a …